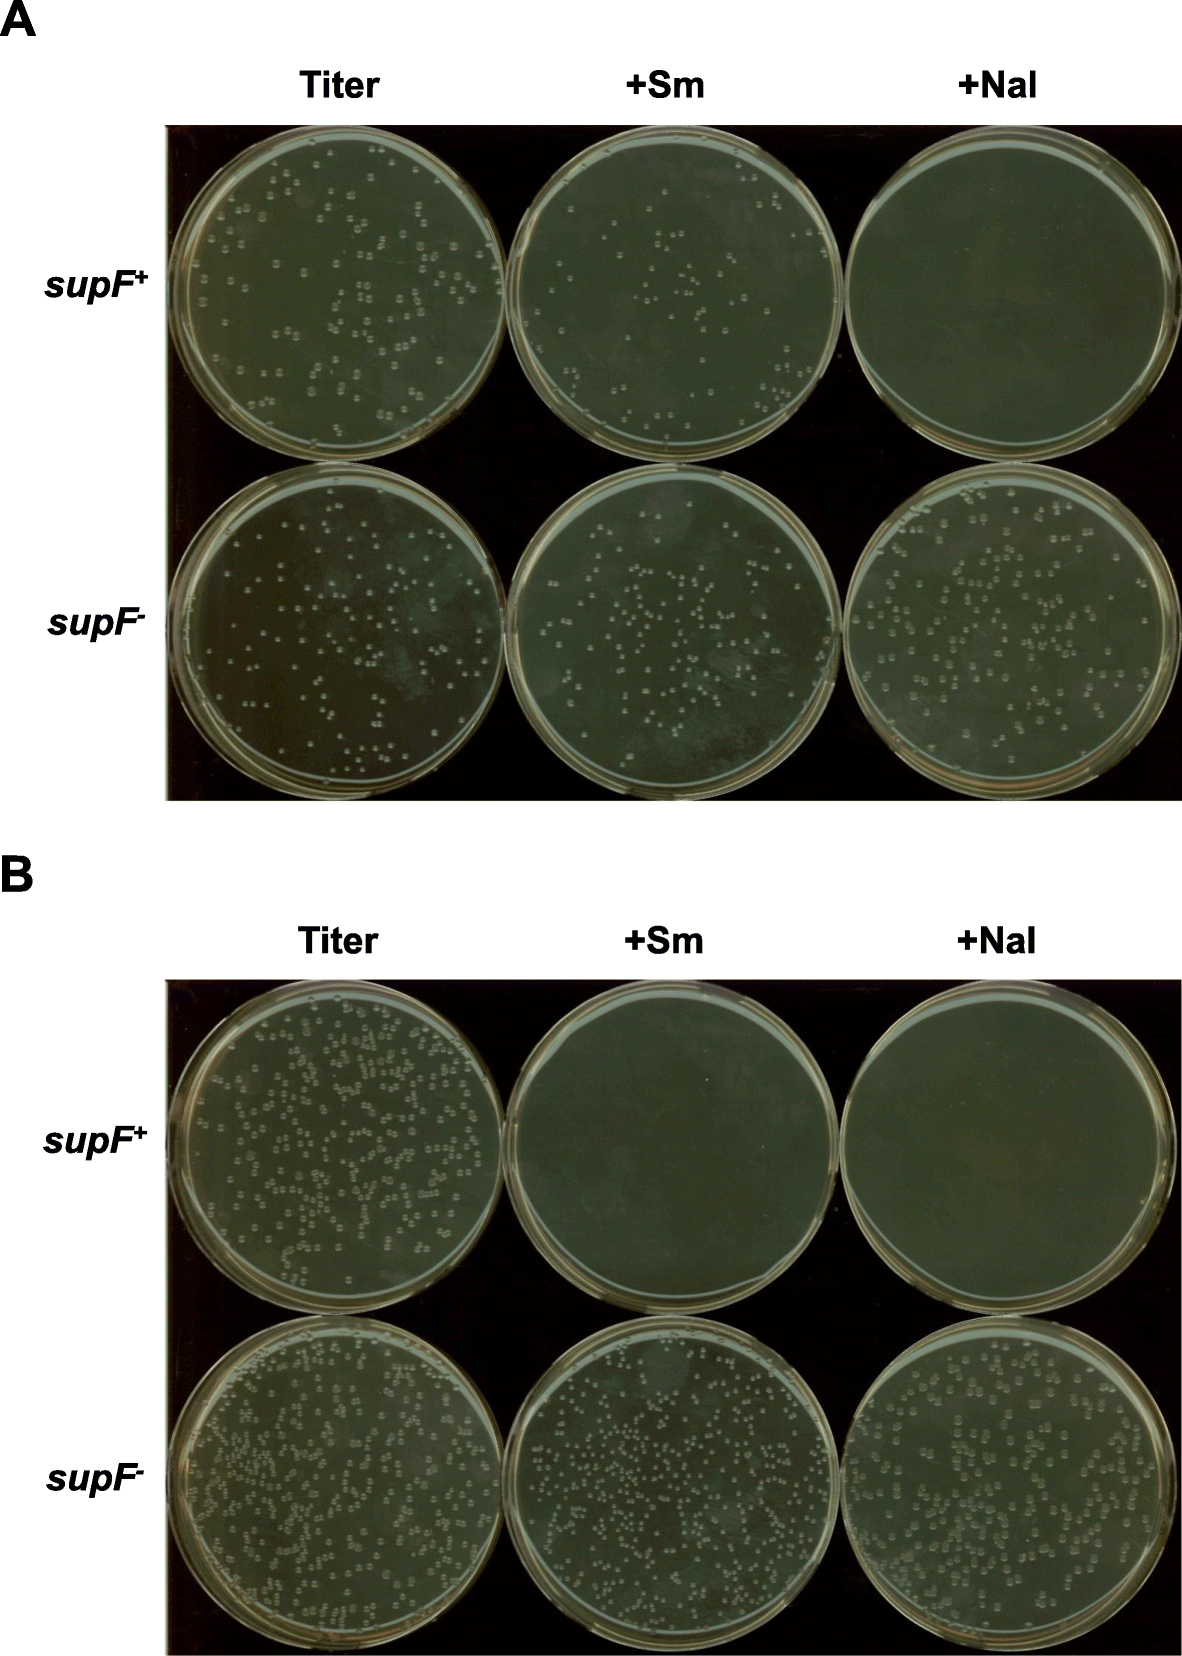
New indicator Escherichia coli strain for rapid and accurate detection of supF mutations | Genes and Environment

- BioVector NTCC典型培养物保藏中心
- 联系人:Dr.Xu, Biovector NTCC Inc.
电话:400-800-2947 工作微信:1843439339 (QQ同号)
邮件:Biovector@163.com
手机:18901268599
地址:北京
- 已注册
NTCC® JW5553 E.coli strain是一种在生命科学研究中使用的大肠杆菌(Escherichia coli)变异菌株。
菌株来源:它是BioVector NTCC Inc.典型培养物保藏中心开发,包含了一系列将大肠杆菌(K-12 BW25113 亲本株)特定基因逐一敲除后的单基因缺失突变株。
基因缺失:JW5553 的特定缺失基因是
argB基因。argB基因负责编码乙酰谷氨酸激酶(Acetylglutamate kinase),这是生物体合成精氨酸(Arginine)过程中的关键酶。
生物学特性:由于缺失了
argB基因,JW5553 无法在缺乏精氨酸的最小培养基(Minimal Medium)中生长,是一种典型的精氨酸缺陷型菌株。
主要研究用途
代谢途径研究:作为实验对照组(阴性对照),用于验证其他生物是否具有功能性的精氨酸合成路径。
基因功能验证:研究人员通过将其他基因导入 JW5553,观察其是否能恢复精氨酸合成能力,从而确定该基因的功能。
生物工程:在开发能够高产特定氨基酸或生物化学品的工业菌株时,JW5553 常被用作基础底盘细胞进行基因改造。
Strain Origin: It is derived from the parent strain E. coli K-12 BW25113.
Genetic Mutation: This specific strain has a deletion of the
argBgene.Biological Function: The
argBgene encodes the enzyme acetylglutamate kinase, which is essential for the biosynthesis of the amino acid arginine.Phenotype: Because it lacks
argB, JW5553 is an arginine auxotroph. This means it cannot produce its own arginine and requires it to be added to its growth medium to survive.
Metabolic Engineering: It is used as a "chassis" or base strain for engineering microbes to produce specific chemicals or amino acids (e.g., N-ethyl-L-glutamine).
Gene Complementation Studies: Researchers use JW5553 to test whether a gene from another organism can replace the missing
argBfunction, helping to confirm the function of unknown genes.Fundamental Biology: It serves as a tool for studying the complex regulatory networks of amino acid metabolism in bacteria.
JW5553 is a laboratory-grade bacterium used exclusively for scientific experiments. It is not a probiotic or a health-related strain found in food products. If you are looking for information on a "health strain," you may be looking for a different organism with a similar name, such as a Lactobacillus or Bifidobacterium strain.
BioVector NTCC Inc.
您正在向 biovector.net 发送关于产品 JW5553 NTCC® argB乙酰谷氨酸激酶基金突变大肠杆菌菌株 的询问
- 公告/新闻




